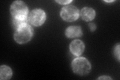
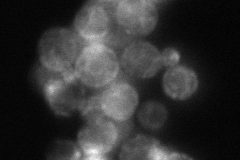

View description
Membrane protein that interacts with Yip1p to mediate membrane traffic; interacts with Sey1p to maintain ER morphology; overexpression leads to cell death and accumulation of internal cell membranes
Localization:
Intensity:
Fold change:
Significance:
-
C’ GFP library in SD
punctate:ER131.35 -
N' NOP1pr-GFP in SD

cell periphery,ER,bud163.148 -
N' TEF2pr-mCherry in SD

cell periphery,ER,bud379.639 -
N' NATIVEpr-GFP in SD
cell periphery,ER,punctate75.4678 -
N' TEF2pr-VC and Cyto-VN in SD

#N/A0 -
C’ GFP library in SD+DTT

punctate.ER167.861.27No -
C’ GFP library in SD+H2O2

punctate.ER149.241.13No -
C’ GFP library in Starvation Media

punctate,ER263.212Yes -
C’ GFP library on the background of Pup2-DaMP

punctate:ER -
C’ GFP library on the background of CCT mutant

punctate:ER119.6380.910776No
